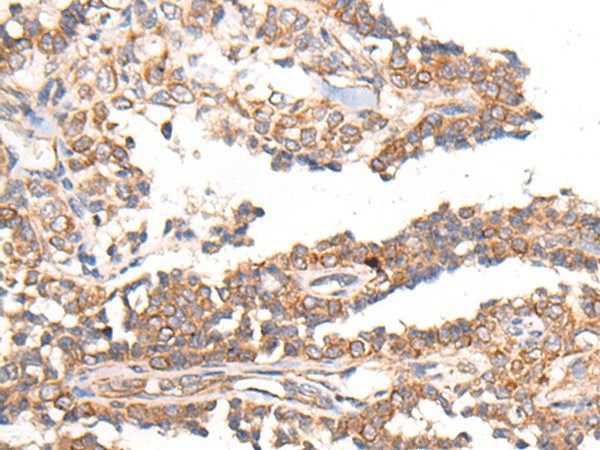
Валидация Elabscience E-AB-53402

| UNIPROT | P49286 |
| Иммуноген | Синтетический пептид, соответствующий человеческому MTNR1B |
MTNR1B Polyclonal Antibody (E-AB-53402)
Реактивность подтвержденная:
человек
Источник (хозяин):
кролик
Валидировано для:
IHC
Характеристики
Техническое описание
| Каталожный номер | E-AB-53402 |
| Название антигена | Melatonin Receptor 1B (MTNR1B) |
| UNIPROT | P49286 |
| Иммуноген | Синтетический пептид, соответствующий человеческому MTNR1B |
| Английские синонимы | MT2, MEL-1B-R |
| Русские синонимы | MT2 |
Реактивность подтвержденная Нужна другая реактивность? |
человек |
| Источник (хозяин) | кролик |
| Изотип | IgG |
| Клональность | поликлональное |
| Рекомбинантное | нет |
| Готовое к использованию | нет |
| Концентрация | 1 мг/мл |
| Конъюгат | нет |
| Валидировано для | IHC Иммуногистохимия |
| Рекомендуемые разведения | IHC 1:30-1:150 |
| Метод очистки | Аффинная очистка с антигеном |
| Состав буфера | PBS с 0.05% NaN3 и 40% глицерин,pH7.4 |
| Условия доставки | термобокс с аккумуляторами холода |
| Условия хранения | Хранить при -20°C - 12 месяцев. Избегать повторяющихся циклов замораживания/оттаивания |
| Срок хранения | 12 месяцев |
| Производитель | Elabscience |
| Ссылка на страницу товара на сайте производителя | https://www.elabscience.com/p-mtnr1b_polyclonal_antibody-e_ab_53402 |
|
Артикул
|
Наименование |
Производитель
|
|---|
|
Артикул
|
Наименование |
Производитель
|
|---|
Акции и предложения
Популярные продукты:
Mouse Antithrombin III(AT III) ELISA kit (E03A1970)
Организм: мышь
Sheep Vitamin E (VE) Elisa kit (E14V0032)
Организм: овца
Chicken Interleukin 2 ELISA kit (E12I0308)
Организм: курица
Диапазон определения: 50-1000 пг/мл
Чувствительность: 1 пг/мл
Диапазон определения: 50-1000 пг/мл
Чувствительность: 1 пг/мл
Recombinant Human IL2 Protein, C-His (YHF36801)
Источник (хозяин): E.coli
Организм: человек
Фрагмент: Ala21-Thr153
Теги: C-His
Биоактивность: нет
Организм: человек
Фрагмент: Ala21-Thr153
Теги: C-His
Биоактивность: нет
PerCP/Cyanine5.5 Anti-Mouse CD19 Antibody[1D3] (FCE1319)
Источник (хозяин): крыса
Реактивность подтвержденная: мышь
Валидировано для: FCM
Реактивность подтвержденная: мышь
Валидировано для: FCM